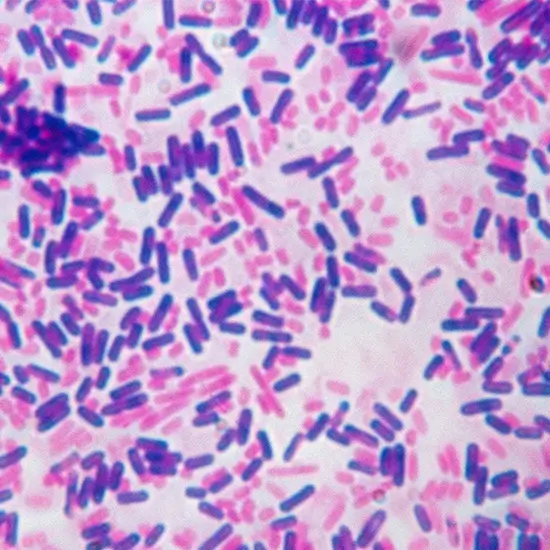

Book Gram Stain Appointment Online Near me at the best price in Delhi/NCR from Ganesh Diagnostic. NABL & NABH Accredited Diagnostic centre and Pathology lab in Delhi offering a wide range of Radiology & Pathology tests. Get Free Ambulance & Free Home Sample collection. 24X7 Hour Open. Call Now at 011-47-444-444 to Book your Gram Stain at 50% Discount.
A Gram stain is a test that examines for bacteria in places like the throat, lungs, genitals, or skin wounds where an infection is suspected. For example, blood or urine can be tested with Gram stains for bacteria.
To detect and classify bacteria or occasionally fungus (microbes) in a sample taken from the suspected infection site; to classify bacteria cultivated in culture to perform additional identification tests and administer appropriate treatment.
Gram stains can be applied to a variety of samples. Sterile swabs are sometimes used to extract cells or exudate from the probable infection location. Clean containers can collect other samples, such as urine or sputum. A needle and syringe may be used to collect some bodily fluids. Bacteria can be isolated and grown in culture using a swab.
A Gram stain does not necessitate any extra preparations.
Most of your symptoms will go away quickly after the needle is put in. You might feel a little pain or bruise where the needle was.
The Gram Stain test cost varies INR 200 to INR 1200 by region and facility. So constantly get tested at trustworthy diagnostic centers like Ganesh Diagnostic. It is staffed by trained and experienced professionals to assure patient and visitor safety.
| Test Type | Gram Stain |
| Includes | Gram Stain Test (Microbiology) |
| Preparation | |
| Reporting | Within 24 hours* |
| Test Price |
₹ 350
|

Early check ups are always better than delayed ones. Safety, precaution & care is depicted from the several health checkups. Here, we present simple & comprehensive health packages for any kind of testing to ensure the early prescribed treatment to safeguard your health.